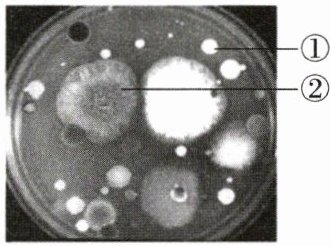

12. 在野外考察时,可将一些特征作为判断藻类、苔藓、蕨类和种子植物的依据。下列有关叙述,正确的是(
A.生活在水中,能进行光合作用的是藻类
B.茎中有导管、叶中有叶脉的是苔藓植物
C.种子有种皮、胚和胚乳的一定是裸子植物
D.用孢子繁殖,叶背面有孢子囊的是蕨类植物
D
)A.生活在水中,能进行光合作用的是藻类
B.茎中有导管、叶中有叶脉的是苔藓植物
C.种子有种皮、胚和胚乳的一定是裸子植物
D.用孢子繁殖,叶背面有孢子囊的是蕨类植物
答案:
12. D
13. 科学家通过组织培养技术制造“胚状体”,以褐藻酸明胶作为包埋介质,填充营养物质,外面用有机膜密封制备成“人工种子”(如图)。下列相关叙述不正确的是(

A.“人工种子”外部的薄膜相当于种皮
B.胚状体相当于新植物的幼体
C.填充的营养液相当于玉米种子的子叶
D.胚状体在萌发过程中能不断分裂产生新细胞
C
)A.“人工种子”外部的薄膜相当于种皮
B.胚状体相当于新植物的幼体
C.填充的营养液相当于玉米种子的子叶
D.胚状体在萌发过程中能不断分裂产生新细胞
答案:
13. C
14. 下列关于几种无脊椎动物的叙述,错误的是(
A.软体动物身体柔软,大多具有贝壳
B.环节动物身体分节,比线虫动物运动灵活
C.海参与海胆一样,都生活在海洋中,属于棘皮动物
D.刺胞动物身体呈辐射对称,可以从各个方向捕获猎物、进行防御,身体结构比环节动物复杂
D
)A.软体动物身体柔软,大多具有贝壳
B.环节动物身体分节,比线虫动物运动灵活
C.海参与海胆一样,都生活在海洋中,属于棘皮动物
D.刺胞动物身体呈辐射对称,可以从各个方向捕获猎物、进行防御,身体结构比环节动物复杂
答案:
14. D
15. 生活在不同环境中的动物由不同的方式获得氧。下列叙述错误的是(
A.鲸生活在海洋中,通过鳃进行气体交换
B.草履虫依靠表膜获取水中的氧,排出二氧化碳
C.鲤鱼的呼吸器官是鳃,它可通过鳃从水中获取氧
D.青蛙幼体用鳃呼吸,成体用肺呼吸且皮肤可以辅助呼吸
A
)A.鲸生活在海洋中,通过鳃进行气体交换
B.草履虫依靠表膜获取水中的氧,排出二氧化碳
C.鲤鱼的呼吸器官是鳃,它可通过鳃从水中获取氧
D.青蛙幼体用鳃呼吸,成体用肺呼吸且皮肤可以辅助呼吸
答案:
15. A
16. 结构与功能相适应是生物学的基本观念,下列叙述正确的是(
A.爬行动物体表覆盖角质的鳞片或甲,能减少体内水分蒸发
B.家鸽的气体交换的器官是肺和气囊,适于空中飞行时获得更多的氧气
C.蝗虫腹部有气门,是气体交换的结构
D.蚯蚓体表有角质层,可以防止土壤摩擦,起保护作用
A
)A.爬行动物体表覆盖角质的鳞片或甲,能减少体内水分蒸发
B.家鸽的气体交换的器官是肺和气囊,适于空中飞行时获得更多的氧气
C.蝗虫腹部有气门,是气体交换的结构
D.蚯蚓体表有角质层,可以防止土壤摩擦,起保护作用
答案:
16. A
17. 下列关于无脊椎动物与人类生活的关系,叙述不正确的是(
A.果蝇是经典的实验动物,许多重要的科研成果都与它分不开
B.从节肢动物蛭中提取的蛭素可生产抗血栓药物
C.蝗虫啃食农作物,可引发蝗灾,会降低农作物产量甚至造成绝收
D.蚯蚓排出的粪便中含有丰富的氮、磷、钾等养分,能够提高土壤肥力
B
)A.果蝇是经典的实验动物,许多重要的科研成果都与它分不开
B.从节肢动物蛭中提取的蛭素可生产抗血栓药物
C.蝗虫啃食农作物,可引发蝗灾,会降低农作物产量甚至造成绝收
D.蚯蚓排出的粪便中含有丰富的氮、磷、钾等养分,能够提高土壤肥力
答案:
17. B
18. 如图是培养空气中细菌和真菌的结果,下列有关叙述错误的是(
A.①是细菌菌落,②是真菌菌落,它们都是由一个细菌或真菌繁殖后形成的
B.培养基可以为细菌或真菌提供有机物
C.接种时将培养皿盖打开,在空气中暴露5~10分钟即可
D.细菌菌落通常比真菌菌落大,呈现各种形状和颜色
D
)A.①是细菌菌落,②是真菌菌落,它们都是由一个细菌或真菌繁殖后形成的
B.培养基可以为细菌或真菌提供有机物
C.接种时将培养皿盖打开,在空气中暴露5~10分钟即可
D.细菌菌落通常比真菌菌落大,呈现各种形状和颜色
答案:
18. D
查看更多完整答案,请扫码查看